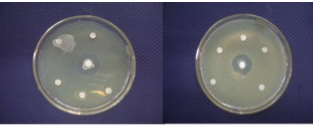

Advances in Animal and Veterinary Sciences
Research Article
Adv. Anim. Vet. Sci. 4 (5): 230 - 236
Figure 1
South Andaman map showing study area
Figure 2
Similarity between the proximal, middle and the distal mangrove zones in Carbyn’s Cove and group average
Figure 3
Microbial community structure in the mangrove zones: Permutation distribution of the test statistic R
Figure 4
Antibacterial activity of Streptomyces sp. against pathogens
Figure 5
Antimicrobial activity of the isolates (zone of inhibition in mm)